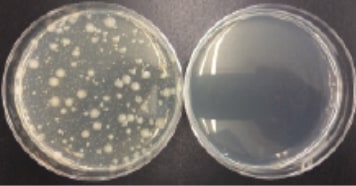
1)大腸菌(左:非稼働 / 右:稼働)
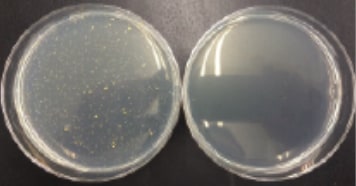
2)黄色ブドウ球菌(左:非稼働 / 右:稼働)
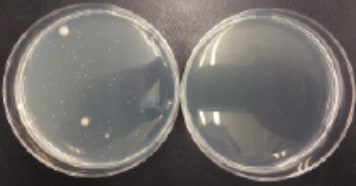
3)緑膿菌(左:非稼働 / 右:稼働)
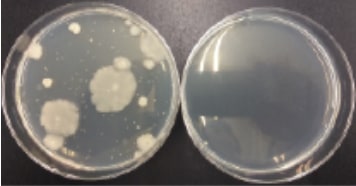
4)枯草菌(左:非稼働 / 右:稼働)

自宅など慣れた環境から出ると、状況は一変し、そのリスクは高まります。そんな時、オゾバリアはオゾンのバリアでいつでもどこでもあなたのプライベート空間を快適に保ち、身の周りの気になるニオイや花粉・ウイルスなどを脱臭・除菌します。













オゾンを発生させるプレート部分にはチリや埃が付着し、オゾン効果を低減させる場合があります。
定期的にプレートを新しいものに交換するだけで常に安定したオゾンを効果的に放出する事ができます。
プレートの交換時期を教えててくれる、メンテナンスお知らせ機能もあります。
[ MGプレートについて ]
24時間利用し続けた場合、1ヶ月間の利用が可能です。
※使用状況により変動します。
オフィスでの
デスクワーク


車や電車
飛行機の中で
リビング


カフェ
宿泊先
ホテル


クローゼット
シューズボックス
オゾンの強い酸化力は、除菌や脱臭において、その威力を発揮します。細菌や悪臭物質の成分の多くは、酸素原子と非常に反応が速く、オゾンによる除菌・脱臭はとても効果的です。
低濃度のオゾンは人体に有益ですが、高濃度のオゾンは一般的に無人環境で短時間に効果を得る場合に使われています。オゾバリアは、人体に影響のない環境基準以下の低濃度オゾンを安定的に発生させる事で安心・安全に効果を発揮します。






オゾバリアによる新型コロナウイルス(SARS-CoV-2:2019-nCoV JPN/TY/WK-521株)の不活化効果の効果についてのプレスリリースが開発元のメーカーサイトに掲載されています。
※以下のリンクは外部サイトへ移動します。
日本スギ(Cryptomeria japonica)の成熟雄花から採集した未精製の花粉を使用し、スギ花粉に対する効果を実証試験を致しました。

シャーレに大腸菌、黄色ブドウ菌、緑膿菌、枯草菌の菌液をそれぞれ1ml添加したものを試料とし、試験ボックス内に静置し、稼働させないものと稼働させたもの、4時間後の生菌数を測定。

試験ボックス内にアンモニアおよびメチルメルカプタンを添加し、対象の検知管を用いて試験ボックス内の濃度を測定し0分時の測定値とした。0分時の測定値後に対象機器を作動させ、経過時間(30、60、120、180分)ごとに試験ボックス内のガス濃度を測定。また対象機器を作動させずに同様の試験を行い対照とした。
| 経過時間(分) | |||||
|---|---|---|---|---|---|
| 装置状態 | 0 | 30 | 60 | 120 | 180 |
| 未稼働 | 39 | 19(49%) | 15(38%) | 13(33%) | 8(21%) |
| 稼働 | 39 | 16(41%) | 10(26%) | 8(21%) | 3(8%) |
測定単位:ppm ()内は0分時を100%とした場合の減衰率
| 経過時間(分) | |||||
|---|---|---|---|---|---|
| 装置状態 | 0 | 30 | 60 | 120 | 180 |
| 未稼働 | 7 | 5(71%) | 5(71%) | 5(71%) | 4(57%) |
| 稼働 | 7 | 0.5(7%) | <0.1 | <0.1 | <0.1 |
測定単位:ppm ()内は0分時を100%とした場合の減衰率
タバコの煙を消煙効果の実証実験を行いました。